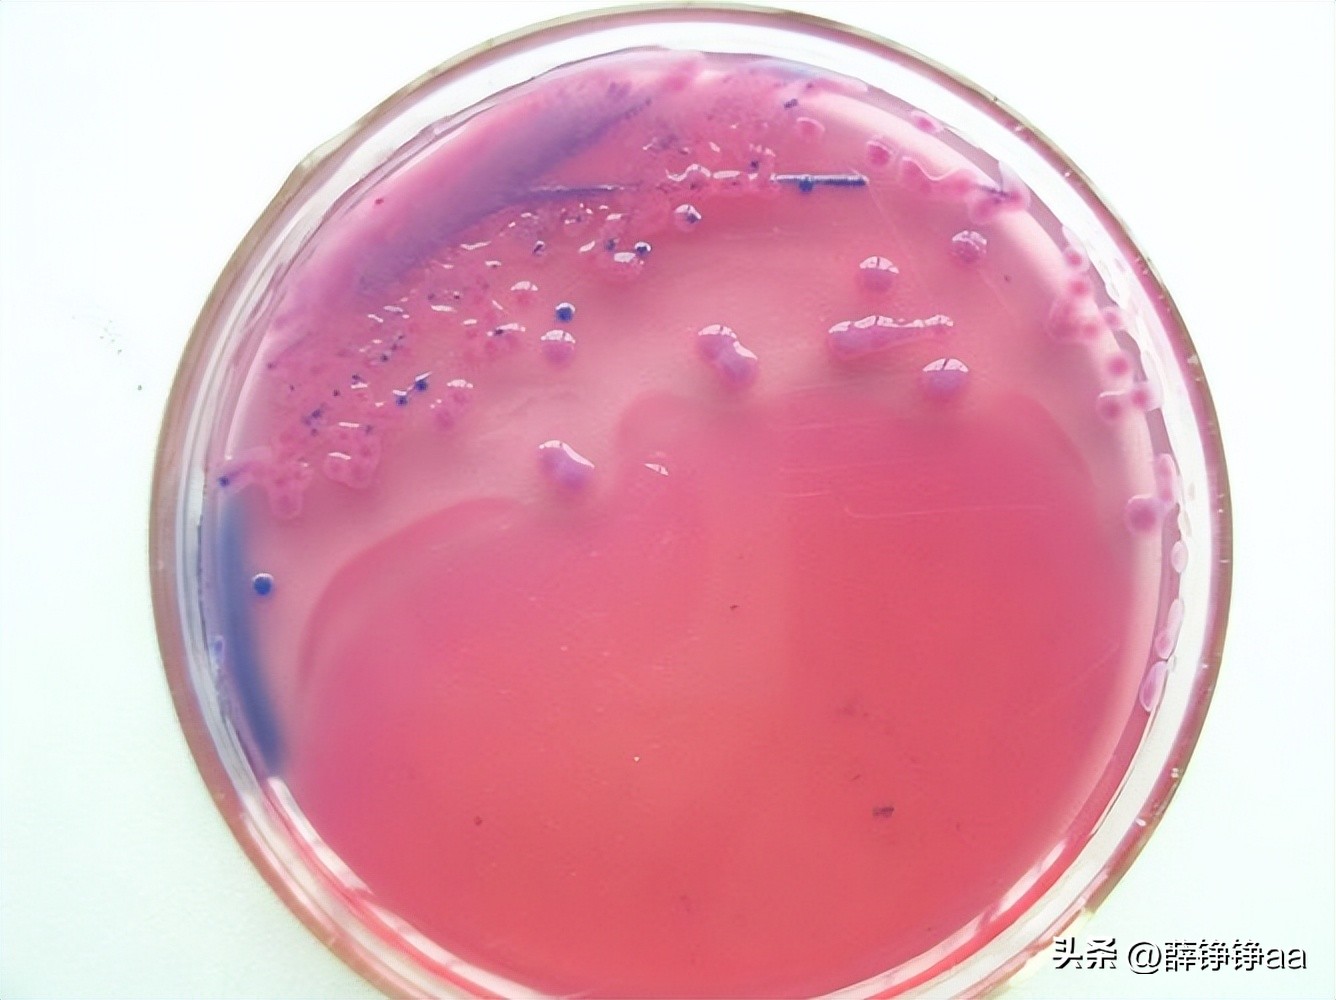
怎样辨别细菌肠胃炎,拉曼光谱法在药品检测中的应用

点击右上方关注,解锁每天好文章
文 | 薛铮铮aa
编辑 | 薛铮铮aa
胃肠炎是一种常见的消化系统疾病,其发病原因往往与细菌感染有关。为了提高胃肠炎的诊断准确性和效率,研究人员探讨了一种新的方法——运用 二维低分辨率拉曼光谱 来鉴别引起胃肠炎的细菌。
通过对多种细菌样本进行实验,并借助先进的数据分析技术,成功实现了对不同细菌株快速、准确的鉴定。
该方法具有非侵入性、无需培养以及高效性等优势,有望在今后得到广泛运用。

在大多数情况下,使用传统的微生物学方法,来鉴定引起胃肠炎的细菌通常是非常高效。然而,高成本的化学试剂以及鉴定所需的长时间(约为四天)可能会给患者带来严重后果。
因此,寻找低成本的光谱学方法来实现对这些微生物的快速、无试剂鉴别,是具有极其重要的意义的。
光谱技术
引起胃肠炎的主要微生物有: 大肠杆菌、霍乱沙门氏菌和弯曲沙门氏菌,针对每种微生物,使用不同的生理溶液作为溶剂,制备了六十种分散液,并记录了它们的拉曼光谱。
用这种方法获得的一维光谱十分相似,这使得微生物的区分变得非常困难。不过,通过应用2D的相关技术,可以在较短时间内(约10小时),对将被评估的微生物进行鉴别,实现“整个生物指纹”的识别。

细菌性胃肠炎的流行是夏季期间一个非常常见的情况,这种感染在儿童、老年人以及有着某些免疫缺陷的患者中高度流行,甚至这些患者可能因感染而受到 致命的影响 。
而在治疗这种疾病时遇到的主要困难便是对于感染再生的确认,如果确认了感染源,便可以选择最佳的抗生素进行治疗。
通常情况下,使用传统的的生物学方法来鉴定细菌类型所需的时间约为四天。但在识别复苏的时间上稍有延迟就可能产生严重的后果,甚至导致患者死亡。

虽然同时使用四种抗生素的方法是必要的,但可能不一定有效,甚至可能增加这些细菌对这些抗生素的抗药性。
一旦出现饵相互作用,就会对人体产生巨大的风险,使这些细菌可能引发难以控制的流行病。
因此,开发出一种能够在固体或液体培养基中,快速区分细菌的新型分析方法是十分必要的。

在目前一些分子生物学技术得到充分发展的情况下,已经能够做到识别病原稳定性和非病原稳定性。
这些方法大多基本上都利用DNA扩增方法和免疫来鉴别的细菌类型,然而,在DNA扩增阶段的复制可能会产生假阳性或假阴性的结果。
然而,使用还处于开发中的 红外显微光谱技术 ,就可以在引起的时间间隔内(约6小时),达到区分灭菌的良好效果。
同时,在研究中使用表面增强拉曼光谱(SERS)的方法,就可以短时间内取得良好的区分效果。

不足与改进
只是为了将这种技术运用更广阔的领域里,还有一个不得不面对的问题,那便是—— 显微光谱仪的高成本。
因此,开发简单的光谱方法,减少的样品处理和特殊试剂的使用量,便成了当下亟需解决的难题。
低分辨率拉曼光谱(LRRS)就在这时候进入了研究人员的视线。

低分辨率拉曼光谱(LRRS)是在考虑拉曼光谱定义的情况下,来定性分析应用的良好选择。
它的剩余性、便携性、使用近红外范围的激光,以及与器件的连接,使得其几乎可以在任何条件下进行在线和原位测量。
除此之外,LRRS最显著的特点是与近红外光谱(NIR)的相似性,而夜间正是分析化学中运用最广泛的光谱技术。
与NIR相似,LRRS中观察到的吸收带也是高速的,这是由拉曼光谱仪的低分辨率(约15 cm-1)造成的。

只是,与NIR不同,LRRS中的这些带是基于振动而跃迁的,如果使用NIR却做不到这点,因此,在NIR中并不能清晰解析所有光谱特征。
另外,由于在LRRS中并不会出现NIR光谱中由于强水吸收造成的干扰,这便增加了在生物医学和生物分析领域中分析应用的可能性。
不过与NIR光谱一样,LRRS光谱也需要使用化学计量方法,从光谱中获取定量或定性信息。

广义二维光谱
1993年由野田功提出的 广义二维光谱技术 现在已经成为一项成熟的技术,而这项技术也特别受到振动光谱学家的欢迎。
双维拉曼光谱是一种在LRRS中广泛运用的化学测量方法,该方法利用额外的一个维度来表示光谱,也因此可以获取有关光谱带重叠和瞬时的信息,而这些在复杂的一维光谱中却很难观察到。
二维光谱的关键在于分析动态光谱,即在频率域内部分析因外部扰动,而在时间范围内发生变化的光谱特性。

这些干扰可以是各种性质的:电学的、化学的、机械的、交叉的或其他的。在这项工作中,随着使用的生理盐水浓度的增加,干扰也在急剧增加,这导致了细菌酰胺基团的非线性响应,而这同时也是这项工作的关键部分。
2D相关光谱基本上包括两种类型的相关光谱,同步(F(n1, n2))光谱和平行(Y(n1, n2))光谱。
因此,同步光谱可以通过平均中心化的光谱矩阵(光谱在行中),以及由动态光谱(n)定义的点积(方程1)来获得:

其中,n为样本数量,v为波数(cm-1)。
稀疏光谱是原始均值中心化的动态光谱的光谱矩阵与正交矩阵的叉积,由以下公式定义(方程2):

其中,Nk,j是Hilbert-Noda矩阵,由以下公式定义(方程3):

基本上,同步光谱包含有关同相变化的信息,而非同步光谱则提供有关不同相变化的光谱差异信息。
同步光谱显示数据的总体差异,可以轻松地将区域划分为重叠的带,而如果带不重叠,对于分析复杂系统而言,则一维光谱更有价值。
生长条件和细菌分散体
为了证实这一研究,实验人员将大肠杆菌(ATCC 25922)、霍乱沙门氏菌(ATCC 13312)和曲志贺菌(ATCC 12022)分别播种在含有 Agar-Mueller Hinton 培养基的培养皿中,并在固体细菌箱中以36.5℃的温度进行培养培养10小时。
10小时后,使用无菌塑料环收集含有最多细菌的培养基,并分散在等渗透生理盐水中,当细菌分散在等渗透介质中时,溶液变得浑浊。
此时再使用 麦克法兰德标度 来关联分散在等渗透溶液中的细菌数量,通过将细菌分散物的浑浊度与法兰德标度的标准进行比较,可以很好地估计出分散在等渗透介质中的细菌数量。
之后再向含有1.1毫升等渗出液的石英比色皿中,分别连续加入60次100微升的增量,每次都加入总共含有15x10^8个细菌/毫升的原始分散液,这一操作对于各大病原体细菌类型都重复进行。
在经过初步测试后,发现了以下结论,小曲因连续添加,产生了高浓度的雷利分散液,以及由于梯度分散液而引起的弱拉曼信号。
通过遵循这个结论,可以得到从0到1.4x10^8个×/毫升的不同分散物,如下图所示:

拉曼测量和样本集
为此,研究人员将使用Ocean Optics低分辨率拉曼光谱仪mod-R-2001进行拉曼光谱收集,并搭载近红外785纳米多模激光激光器,在样品输出上的功率调整为300毫瓦。
同时配备热电冷却的2048元件CCD阵列,来测量200至2800 cm-1范围内的光谱,总体光谱分辨率约为15 cm-1。
该仪器使用异丙醇进行波长调整,所有获得的光谱均减弱了暗电流。

除此之外,为了使本研究中评估的所有细菌分散液、所有细菌以及真菌细菌均获取三个低分辨率拉曼光谱,在积分时间为10秒的情况下,最终光谱被视为这三个光谱的溶剂,并从每一种细菌获取了60个光谱。
紧接着,再按细胞浓度递增顺序对这些光谱进行排列,使用R-base软件(版本3.0.1)进行光谱仪控制,显示出了大肠杆菌、霍乱沙门氏菌和曲志贺菌的同等低分辨率拉曼光谱。

除了上述内容,光谱还应经过以下程序进行处理:
首先使用带有Daubechies(db4)基函数的小波滤波器进行噪声最小化,进行两级分割后采用50%的阈值处理。
然后使用Gram-Schmidt方法,从等渗介质对光谱进行范围自动缩放并截取,而选择出圆形胶囊I带(约1680 cm-1),是2D分析的主要关注区域。
这其中,噪声最小化、Gram-Schmidt方法和2D计算/可视化的程序,均通过利用Matlab 4.0中的子程序来实现的。
对光谱的分析
下图展示了大肠杆菌、霍乱沙门氏菌和曲志贺菌的60个低分辨率拉曼光谱,从中可以看出,在添加干扰的过程中光谱的变化相对较小。
此外,不同细菌类型之间的光谱,差异也很小,要想通过仔细分析这些光谱来区分这些细菌, 仅肉眼观察是非常困难的。
为了解决这一难题,研究人员特意在酰胺带的区域获得了2D同步和极性光谱。

之所以会选择这个带,是因为考虑到实验中,细菌的细胞壁都由DNA桥交联的肽链组成。
这些不同的物种,会受到壁中局部酰胺I模式频率,局部短路和溶解的强烈影响,并且还会与周围短路的溶剂分子应答,这会导致肽键的电子和分子结构也随之发生变化。
因此,作为实验关键部分的细菌酰胺基团,应随着细胞浓度的变化而连续做出响应。
在这种情况下,使用 分子动力学模拟方法 的同时,再结合其外推方法,便可以研究出液体中,酰胺I模式频率升降的具体数据。

同时以对异步光谱的分析结果为基础,通过仅分析终点的同步表面,可以对它们进行区分。
从视角表示图光谱的分析中显示,大约在1680 cm-1的区域内,形成了一个同步交叉峰,这表明在大约1700 cm-1的区域,存在高度的酰胺I带,而这个数据在1D光谱中是观察不到的。
这一事实表明,同步化表面中观察到的差异,是由于酰胺基团的溶解作用造成的,它改变了这些阴离子的构象和阴离子间的相互作用,影响了酰胺I模式的频率,而这一发现也可以作为快速检测生物样品中的细菌的强大分析工具。

结论
使用低分辨率拉曼光谱(LRRS)与广义二维相关光谱学(2D-LRRS)相结合的方法,能够鉴别出大肠杆菌、霍乱沙门氏菌和弯曲志贺菌等非常相似的细菌。
但为了确定适合的抗生素治疗,还需要进行抗生素敏感性测试,因为就算是相同类型的菌株也可能具有不同程度的抗药性。
该方法可以用于构建广泛且可靠的 “全细菌指纹”数据库 ,用于快速鉴别各类细菌,并帮助人们采取相应的治疗措施,相信随着该技术的不断发展和改进,它将在人们的生活中发挥越来越重要的作用。
